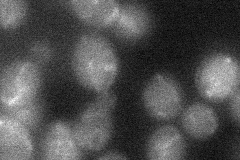
YPL027W

View description
Protein of unknown function involved in the assembly of the prospore membrane during sporulation; interacts with Spo14p
Localization:
Intensity:
Fold change:
Significance:
-
C’ GFP library in SD

below threshold16.53 -
N' NOP1pr-GFP in SD

cytosol,nucleus58.2162 -
N' TEF2pr-mCherry in SD

nuclear periphery10.3062 -
N' NATIVEpr-GFP in SD

below threshold19.2823 -
N' TEF2pr-VC and Cyto-VN in SD
below threshold24.7208 -
C’ GFP library in SD+DTT

cytosol18.371.11No -
C’ GFP library in SD+H2O2

cytosol13.870.83No -
C’ GFP library in Starvation Media

cytosol15.790.95No -
C’ GFP library on the background of Pup2-DaMP

below threshold -
C’ GFP library on the background of CCT mutant

below threshold17.52531.05967No
